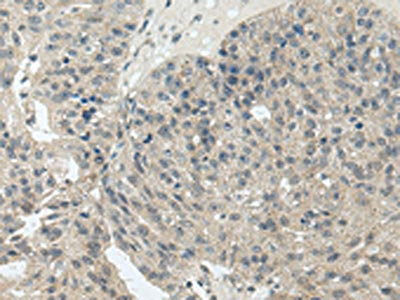

STRA6 Antibody
-
中文名稱:STRA6兔多克隆抗體
-
貨號:CSB-PA800154
-
規(guī)格:¥1100
-
圖片:
-
其他:
產(chǎn)品詳情
-
Uniprot No.:
-
基因名:STRA6
-
別名:MCOPCB8 antibody; MCOPS9 antibody; PP14296 antibody; Stimulated by retinoic acid 6 homolog antibody; Stimulated by retinoic acid gene 6 protein homolog antibody; STRA6 antibody; STRA6_HUMAN antibody
-
宿主:Rabbit
-
反應(yīng)種屬:Human
-
免疫原:Synthetic peptide of Human STRA6
-
免疫原種屬:Homo sapiens (Human)
-
標(biāo)記方式:Non-conjugated
-
抗體亞型:IgG
-
純化方式:Antigen affinity purification
-
濃度:It differs from different batches. Please contact us to confirm it.
-
保存緩沖液:-20°C, pH7.4 PBS, 0.05% NaN3, 40% Glycerol
-
產(chǎn)品提供形式:Liquid
-
應(yīng)用范圍:ELISA,IHC
-
推薦稀釋比:
Application Recommended Dilution ELISA 1:2000-1:5000 IHC 1:25-1:100 -
Protocols:
-
儲存條件:Upon receipt, store at -20°C or -80°C. Avoid repeated freeze.
-
貨期:Basically, we can dispatch the products out in 1-3 working days after receiving your orders. Delivery time maybe differs from different purchasing way or location, please kindly consult your local distributors for specific delivery time.
-
用途:For Research Use Only. Not for use in diagnostic or therapeutic procedures.
相關(guān)產(chǎn)品
靶點(diǎn)詳情
-
功能:Functions as retinol transporter. Accepts all-trans retinol from the extracellular retinol-binding protein RBP4, facilitates retinol transport across the cell membrane, and then transfers retinol to the cytoplasmic retinol-binding protein RBP1. Retinol uptake is enhanced by LRAT, an enzyme that converts retinol to all-trans retinyl esters, the storage forms of vitamin A. Contributes to the activation of a signaling cascade that depends on retinol transport and LRAT-dependent generation of retinol metabolites that then trigger activation of JAK2 and its target STAT5, and ultimately increase the expression of SOCS3 and inhibit cellular responses to insulin. Important for the homeostasis of vitamin A and its derivatives, such as retinoic acid. STRA6-mediated transport is particularly important in the eye, and under conditions of dietary vitamin A deficiency. Does not transport retinoic acid.
-
基因功能參考文獻(xiàn):
- Mutations in retinoic acid 6 gene (STRA6) have been reported in clinically diagnosed patients with MWS. Here we presented a case with MWS, who has characteristic findings of the syndrome as well as dextrocardia as an undescribed feature, and bilateral streak gonads which was described only in one patient previously. Molecular analysis showed a homozygous exonic missense mutation in the STRA6 gene. PMID: 30204971
- The knockdown of STRA6 slightly enhanced nodule formation at the late stage of osteoblast differentiation, and overexpression of STRA6 in ST2 cells enhanced adipocyte differentiation. PMID: 29067460
- these data demonstrate a key role of STRA6 and RBP4 in the maintenance of colon cancer self-renewal and that this pathway is an important link through which consumption of HFD contributes to colon carcinogenesis. PMID: 28689994
- this study suggested that a role of STRA6 polymorphism could also be of value in predicting the risk of type 2 diabetes mellitus(T2DM) while RARRES2 polymorphism could not predict the risk of T2DM PMID: 27446956
- A novel mutation in two Hmong families broadens the range of STRA6-related malformations to include contractures and camptodactyly. PMID: 26373900
- These data establish that holo-RBP and its receptor STRA6 are potent oncogenes and suggest that the pathway is a novel target for therapy of some human cancers. PMID: 25237067
- Evidence for the existence of a transmembrane pore, analogous to the pore of ion channels, in STRA6. PMID: 24223695
- STRA6 has a role for regulating retinoid homeostasis and in helping to program signaling that drives proliferation and differentiation of human skin cells PMID: 24284421
- Stra6, a retinoic acid-responsive gene, participates in p53-induced apoptosis after DNA damage. PMID: 23449393
- Analysis of FRAS1 and STRA6 mutations in the same family with eye anomalies. PMID: 22283518
- Findings suggest that heterozygosity for the STRA6 gene mutation may be associated with ocular abnormalities. PMID: 22686418
- TTR blocks the ability of holo-retinol-binding protein to associate with STRA6 and thereby effectively suppresses both STRA6-mediated retinol uptake and STRA6-initiated cell signaling. PMID: 22826435
- STRA6 orchestrates a multicomponent machinery that couples vitamin A homeostasis and metabolism to activation of a signaling cascade and that, in turn, STRA6 signaling regulates the cellular uptake of the vitamin. PMID: 22665496
- STRA6 mutations can cause isolated eye malformations in addition to the congenital anomalies observed in MWS. PMID: 21901792
- SNPs in STRA6, gene coding the cell surface receptor for RBP4, were significantly associated with type 2 diabetes and further genetic and functional studies are required to understand and ascertain its role in the manifestation of type 2 diabetes. PMID: 20625434
- Mutations in STRA6 cause a broad spectrum of malformations including anophthalmia, congenital heart defects, diaphragmatic hernia, alveolar capillary dysplasia, lung hypoplasia, and mental retardation PMID: 17273977
- Matthew-Wood syndrome is caused by truncating mutations in the retinol-binding protein receptor gene STRA6. PMID: 17503335
- In fibroboasts, STRA6 transports retinol bidirectionally in an RBP4 dependent manner. PMID: 18316031
- study identifies an essential functional domain in STRA6 and a human polymorphism in this domain that leads to reduced vitamin A uptake activity PMID: 18387951
- This study explores the association of STRA6 and SKI genes in a cohort of subjects with anophthalmia and microphthalmia. PMID: 19112531
- Two novel STRA6 mutations in a patient with anophthalamia and diaphragmatic eventration are reported. PMID: 19213032
- Six novel mutations were identified in STRA6. PMID: 19309693
顯示更多
收起更多
-
相關(guān)疾病:Microphthalmia, syndromic, 9 (MCOPS9)
-
亞細(xì)胞定位:Cell membrane; Multi-pass membrane protein.
-
組織特異性:Broad expression. In adult eye expressed in sclera, retina, retinal pigment epithelium, and trabecular meshwork but not in choroid and iris.
-
數(shù)據(jù)庫鏈接:
Most popular with customers
-
-
YWHAB Recombinant Monoclonal Antibody
Applications: ELISA, WB, IHC, IF, FC
Species Reactivity: Human, Mouse, Rat
-
Phospho-YAP1 (S127) Recombinant Monoclonal Antibody
Applications: ELISA, WB, IHC
Species Reactivity: Human
-
-
-
-
-